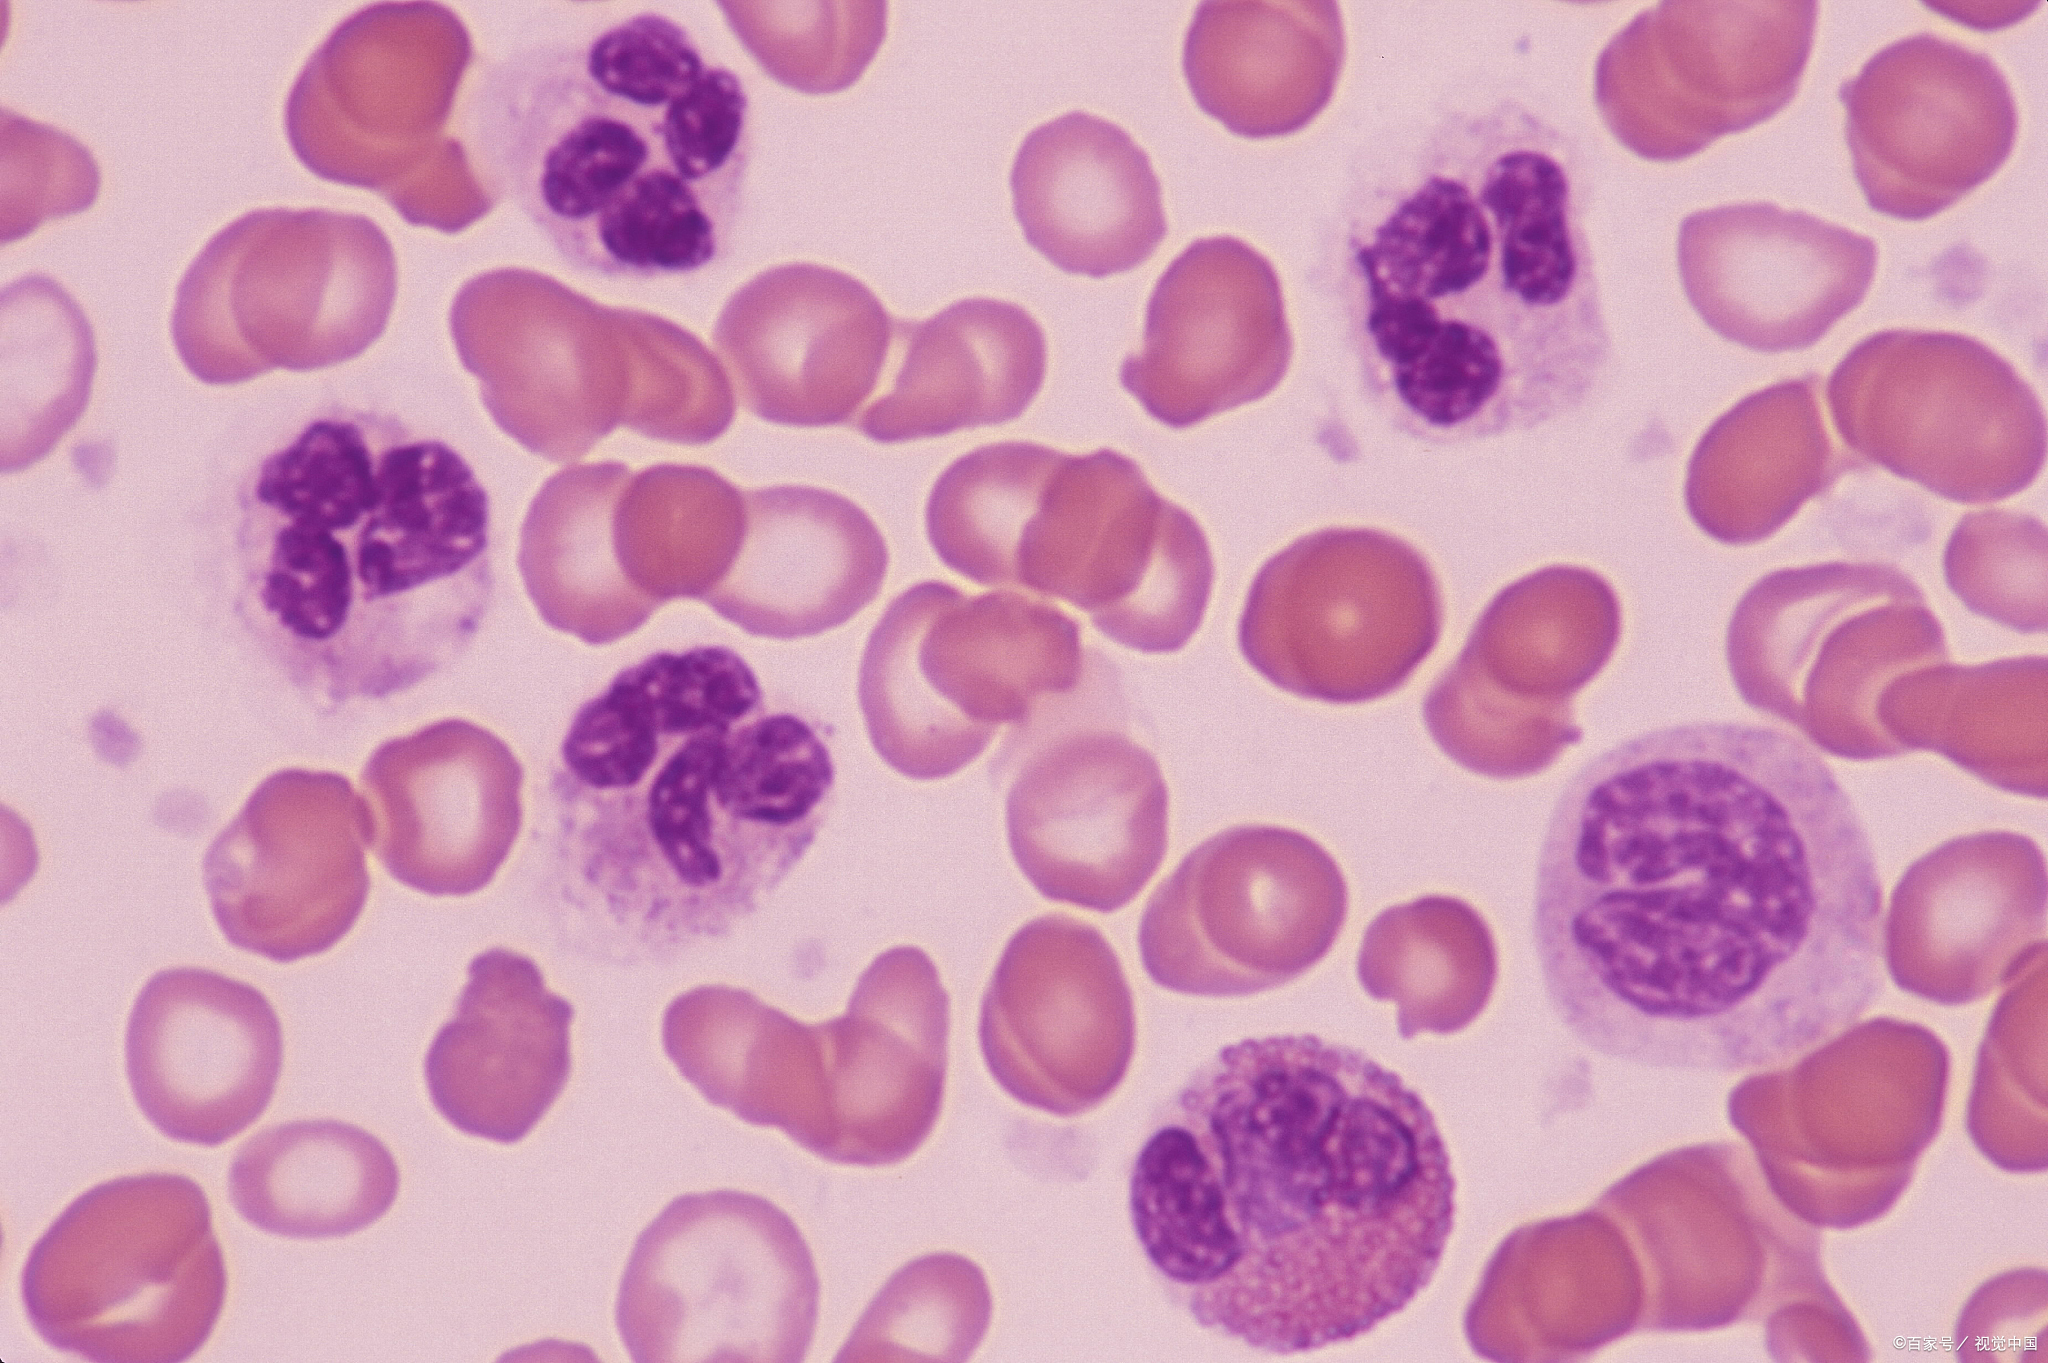
卵巢早衰病因复杂,女性患有卵巢早衰主要表现是什么

卵巢早衰(POF)是指40岁以下的妇女,伴随着促性腺激素水平的增高和雌激素不足,发生率为1%-2%,影响中国育龄妇女。临床表现为:血清雌激素水平下降、血清促性腺激素增高、卵泡几乎或全部消耗。卵巢早衰有两种情况:一是原发性,二是继发性。原发性是指在40岁之前没有出现月经来潮的女性,继发性是指40岁之前出现了停经和高促性激素的女性。由于卵巢早衰所致的原发性或继发性闭经后,随着血促性腺激素水平升高,雌激素水平下降,会导致一系列的低雌激素征象,使其生育率下降,长期发生骨质疏松、心血管病、阿尔兹海默病(AD)、肿瘤等。2014年上海女性健康状况的调查与分析显示,有过卵巢早衰的女性病死率有所上升,应加强对这些群体的监测和早期干预。此外,超过半数的病人出现了间歇性或无法预测的卵巢功能恢复,故在国际上已逐步被称为“卵巢功能不全” POI。

卵巢早衰的患病率
卵巢早衰的发生率在40岁以前是1%,30岁以前是0.1%,20岁以前是0.01%。继发闭经率为4%~18%。原发性闭经率在10%-28%之间。在 POF病人家族中,约20-30%存在其它疾病。与西部高加索(36岁的平均诊断年龄)和塞尔维亚(34.2岁的平均诊断年龄)相比,中国的 POF病人的发病年龄更年轻(平均29.8岁)。该病的发生与人群、营养、环境等因素有关,并表明遗传因素对其发生有一定的影响。与西方高加索(36岁)、塞尔维亚(平均诊断年龄34.2岁)相比,中国 POF的发病年龄较小(29.8岁),其发病时间较早,与种族、营养、环境等因素有关,且与遗传因素有关。

卵巢早衰的主要症状
POF的临床症状以卵巢功能衰竭、雌激素水平低下、生育能力下降为主。卵巢衰竭: POF常以闭经和不孕为主,少数在青春期前出现 POF,常会影响到第二性征的发育; POF出现于青春期后,也就是在月经稀发、过频、不规则的功能紊乱性子宫出血等。低雌激素:近期容易出现焦虑、抑郁、激动、易怒、不能自控等情绪障碍;出现血管舒缩、潮热、出汗等;女性阴道干燥、*交性**困难、反复出现的尿道感染、阴道炎、尿道感染等;长期骨质疏松、心血管疾病、阿尔兹海默病发病率增高的 POF病人,其生育率极低,大多没有自然怀孕的可能。遗传原因包括染色体异常、基因突变、自身免疫、医源性等。
1、POF的主要原因是染色体异常
陈子江等于2011年对中国汉族531名 POF病人进行了核型分析,结果显示,异常发生率为12.1%, X染色体异常占93.7%。45, XO和它的嵌合物[45, XO/46, XX和/或47, XXX], X染色体长臂或短臂缺失, X染色体常染色体易位。X染色体数量最多的是 X单体和 X染色体的嵌合体。47, XXX是一种罕见的病例,其发病率大约为3.8%,并且经常伴随有自身免疫或肾上腺的病变。Xp11.2- p22.1在 POF中的丢失往往与短臂近端 Xp11.2- p22.1有关,说明 Xp11.2- p22.1在卵巢功能中起着重要的作用。先前的 Xq和X-常染色体易位的研究表明 Xq13.3-q26/q27是卵巢功能和生育生命必不可少的重要部位,而 Xq13.3-q26/q27也是 POFl (Xq26-q28)和POF2 (Xql3-q21)。
另外,低水平嵌合、隐匿性重排以及 X染色体的失活等都是常规核型分析无法识别的。2条 X染色体是维持卵巢功能的重要因素。在这些基因中,对卵巢的发育和功能起着至关重要的作用。避免 X染色体失活的这一区域的基因剂量不足、重排对相邻基因有“位置效应”,或者对减数分裂的同源染色体无特异性干扰,都会加速卵泡的闭锁,这是 X染色体异常引起 POF的重要原因。利用X-常染色体平衡易位断裂点和 X染色体节段性丢失的位置,发现了一些与 POF有关的候选基因。但是,一些 X染色体的断裂点不能分裂出任何基因,也不能使其所处的区域内没有编码的基因,因此可以认为, X染色体的易位断裂点对易位到 X染色体上的常染色体上的基因进行了表观修饰。
2、基因突变
原生殖细胞的迁移与增殖这一期的异常会造成生殖细胞的丧失,始基的卵泡池太小。始基卵泡的生成和激活,始基卵泡的发育是由非促性腺激素所决定的,因此,在这一时期,卵母细胞和体细胞的准确协调是关键。早期卵泡发育:这些基因的正确表达对基本的卵泡储存有很大的影响。通过调节卵母细胞与周边体细胞间的关系,使初级卵泡转变为次级卵泡,从而调节卵泡的发育。后期卵泡发育:卵泡发育到后期,在促性腺激素和性激素的刺激下,生长卵泡逐渐成熟。
卵子和颗粒细胞的线粒体 DNA:本研究表明:卵子和颗粒细胞的线粒体 DNA (mt DNA)变异率随年龄的增长而增高;而 POF组的 mtDNA水平明显降低,而卵母细胞 mt DNA的复制数则明显低于正常卵巢功能正常的女性。

3、酶缺陷
半乳糖磷酸盐转移酶不足:半乳糖增加会对卵母细胞造成直接损伤,而其代谢物会对卵巢组织造成损伤。17-α-羟化酶/17,20-裂解酶缺乏:这种病症的妇女,其外阴组织形态正常,临床表现为高血压,低钾血症,高孕酮血症,高促性腺激素性闭经,第二性征不能发育。组织学检查显示,在初生或次生卵母细胞期,卵巢上没有卵泡。
4、免疫因素
自身免疫疾病会导致卵巢损害,也会导致对卵巢组织产生免疫反应,比如肾上腺疾病、甲状腺疾病等。POF病人中,5%为自身免疫性肾炎,10%~30%伴有其它自身免疫疾病。
5、感染因素
卵巢炎、腮腺炎、盆腔结核、淋菌性和化脓性盆腔炎都是由水痘病毒和巨细胞病毒造成的。
6、医源性原因
外科治疗,放射治疗,化疗药物对卵巢的损害是医源性的。
7、卵巢特发性功能不全
卵巢早衰是一种多发性的疾病,其原因十分复杂,除了遗传、感染、免疫、代谢、手术、放、化疗等因素之外,90%以上的病人都没有明确的病因。现有的研究表明, POF更有可能是一种由遗传和环境共同影响的多基因遗传性疾病。